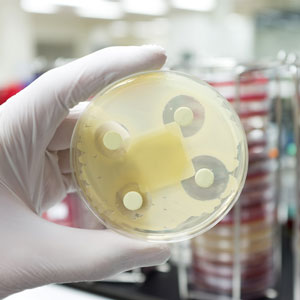
Collaborer pour lutter contre les superbactéries : le projet Résistance aux antimicrobiens - Une seule santé

Collaboration en recherche et en science au sein du gouvernement du Canada. Histoires, personnes, financement, ressources éducatives, prise de décisions fondées sur des données probantes et plus encore.
Science et recherche à l’échelle fédérale
Bureau de la Conseillère scientifique en chef
Mme Mona Nemer est la conseillère scientifique en chef du Canada. Ses priorités sont de s’assurer que les travaux scientifiques du gouvernement fédéral soient accessibles, de veiller à ce que les scientifiques du gouvernement puissent s’exprimer librement et de promouvoir une prise de décision fondée sur des données probantes.
Le Dépôt fédéral de science ouverte du Canada
Accédez au dépôt fédéral d’articles et de publications scientifiques des ministères et organismes à vocation scientifique participants.
Laboratoires Canada est une stratégie pangouvernementale d’une durée de 25 ans qui vise à favoriser davantage la collaboration entre les établissements scientifiques fédéraux et avec les universités, les partenaires internationaux et la population canadienne.
Recherche et financement collaboratifs
Financement interorganismes de la recherche
Renseignez-vous sur la collaboration entre les organismes de financement de la recherche du Canada et obtenez de l’information sur les programmes de financement pour votre recherche.
Protégez votre recherche
Conseils, renseignements et outils pour aider les chercheurs canadiens à protéger leurs recherches et leur propriété intellectuelle.
La recherche, notre avenir
Voyez comment le financement fédéral alloué à la recherche stimule l’innovation.
Autres programmes de recherche collaboratifs
- Alliance de la recherche océanique au Canada (AROC)
- CONCEPTS - Réseau opérationnel canadien de systèmes couplés de prévision environnementale
- Groupe interministériel sur les sciences, la technologie, l’ingénierie et les mathématiques autochtones (STIM-A)
- Mésinformation scientifique
- Programme canadien pour la sûreté et la sécurité
- Programme de lutte contre les contaminants dans le Nord
- Science ouverte
Impliquez-vous
Portail science citoyenne
Renseignez-vous sur les projets scientifiques et sur les expériences dans votre collectivité auxquels vous pouvez participer.
Ressources pédagogiques
Consultez des activités scientifiques, des plans de cours, des vidéos et plus encore pour aider les enfants et les adolescents à en apprendre davantage sur les sciences et la technologie.
Carrières scientifiques
Renseignez-vous sur les possibilités de carrière dans le domaine des sciences au sein du gouvernement fédéral pour les étudiants et pour les professionnels scientifiques.
Histoires de science et de recherche
Collaborer pour lutter contre les superbactéries : le projet Résistance aux antimicrobiens - Une seule santé
4 février 2026
Le jeu des erreurs : la solution aux mauvaises herbes?
22 janvier 2026
Normes d’atténuation du radon : Protection des Canadiens contre un danger invisible
9 janvier 2026
Pièges, arbres et travail d’équipe : la surveillance phytosanitaire au service des espaces verts au Canada
15 septembre 2025
Plus d’histoires scientifiques
En vedette
Le saumon monte en flèche à Parcs Canada
Parcs Canada s’est donné pour mission de revitaliser les populations de saumon, en collaboration avec les communautés autochtones et les partenaires du Canada atlantique, de la Colombie-Britannique et du Yukon.
Médias sociaux
En vedette
Artemis II : faits marquants de la mission
Récapitulation du voyage extraordinaire de l'équipage d'Artemis II.
Recherche en défense au CNRC
Accélérer l’innovation et développer des technologies de pointe à usage civil et militaire.
Horizon Europe
Accédez à des possibilités de financement et des occasions de collaboration internationale par l’entremise d’Horizon Europe, qui se veut le plus important programme de financement de la recherche et de l’innovation au monde.